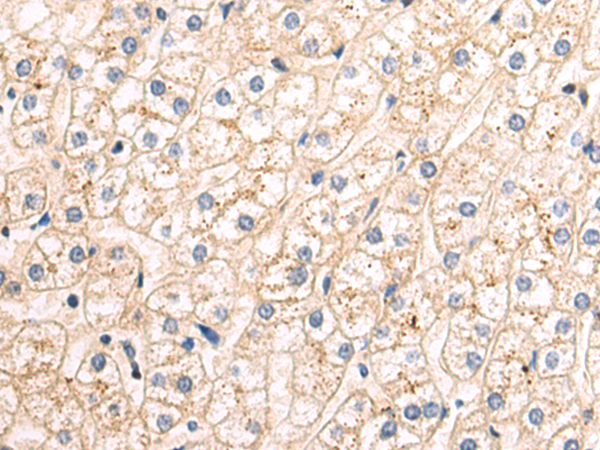

-
分类: 科研抗体货号: P10208别名: BG; MPS7应用: WB,IHC反应种属: Human
-
分类: 科研抗体货号: P10226别名:应用: WB,IHC反应种属: Human
-
分类: 科研抗体货号: P10207别名: EF1D; EF-1D; FP1047应用: WB,IHC反应种属: Human, Mouse, Rat
-
分类: 科研抗体货号: P10225别名: ISK; JLNS; LQT5; MinK; JLNS2; LQT2/5应用: IHC反应种属: Human
-
分类: 科研抗体货号: P10206别名: FIR; FRG; PLEKHC3应用: IHC反应种属: Human, Mouse
-
分类: 科研抗体货号: P10224别名: PCD; PHS; DCOH; PCBD应用: WB,IHC反应种属: Human, Mouse, Rat
-
分类: 科研抗体货号: P10205别名: ARGBP2; PRO0618应用: WB,IHC反应种属: Human, Mouse, Rat
-
分类: 科研抗体货号: P10223别名: PSORS15应用: IHC反应种属: Human, Mouse
-
分类: 科研抗体货号: P10204别名:应用: WB,IHC反应种属: Human
-
分类: 科研抗体货号: P10222别名: CSTF-77应用: WB反应种属: Human

鄂公网安备42018502007531号
鄂公网安备42018502007531号

